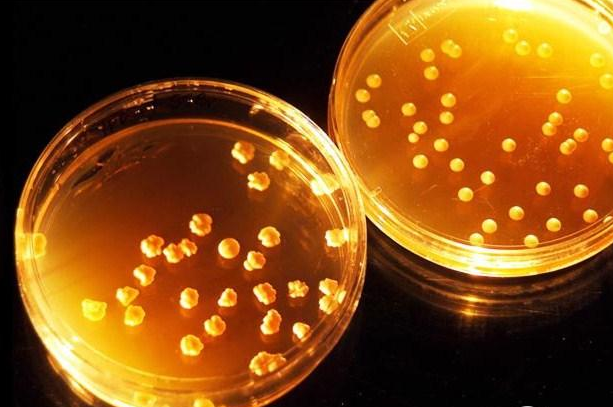
大慶油田利用微生物降解原油生成天然氣

1.1億元 甘肅禮縣餐廚垃圾生物降解處置項(xiàng)目開工儀式舉行
6月15日,禮縣餐廚垃圾生物降解處置項(xiàng)目開工儀式在城關(guān)鎮(zhèn)馮崖村舉行,縣委常委、常務(wù)副縣長楊敬主持開工儀式,縣委常委、統(tǒng)戰(zhàn)部長趙海軍宣布項(xiàng)目開工??h人大常委會副主任張喜琴、政府副縣長張君、縣政協(xié)副主席楊云琴,縣直有關(guān)單位、企業(yè)代表、參建單位等相關(guān)人員參加開工儀式。該項(xiàng)目占地15畝,近期將建設(shè)餐廚垃圾生物環(huán)保處置示范基地,日處理規(guī)模50-100噸,近期投資約3000萬元,中遠(yuǎn)期投資約達(dá)到8000萬元,總投資1.1億元。主要建設(shè)廠房、辦公樓、...

靈活的紙基電池:在被丟棄就能被生物降解
盡管現(xiàn)在有可生物降解的一次性電子設(shè)備如環(huán)境傳感器,但為這些設(shè)備供電的電池仍會造成生態(tài)問題。這就是為什么科學(xué)家們現(xiàn)在創(chuàng)造了一種完全可生物降解的紙基電池。該電池由新加坡南洋理工大學(xué)的一個(gè)團(tuán)隊(duì)開發(fā),尺寸只有4×4厘米--至少,它的一個(gè)版本是這樣的--據(jù)說它能為一個(gè)小電風(fēng)扇供電45分鐘。

金暉兆隆2×6萬噸生物降解聚酯PBAT項(xiàng)目總承包合同簽約儀式在南京舉行
12月27日,金暉兆隆2×6萬噸生物降解聚酯PBAT項(xiàng)目總承包合同簽約儀式在江蘇南京蘇美達(dá)大廈舉行。 山西金暉能源集團(tuán)有限公司副總裁、山西金暉兆隆高新科技有限公司董事長李雅娟,上海聚友化工有限公司董事長丁楊惠勤,蘇美達(dá)成套公司國際工程事業(yè)一部總經(jīng)理葉炬分別代表三方簽約。
大慶油田利用微生物降解原油生成天然氣
近日,大慶油田勘探開發(fā)院實(shí)驗(yàn)中心的微生物采油技術(shù)實(shí)驗(yàn)室里,一瓶瓶裝著黑色液體的“油寶寶”整齊排列在勻速晃動(dòng)的溫暖“搖籃”里睡得好香甜。原來,這個(gè)實(shí)驗(yàn)室正在開展利用微生物降解原油生成天然氣技術(shù)的研究。
